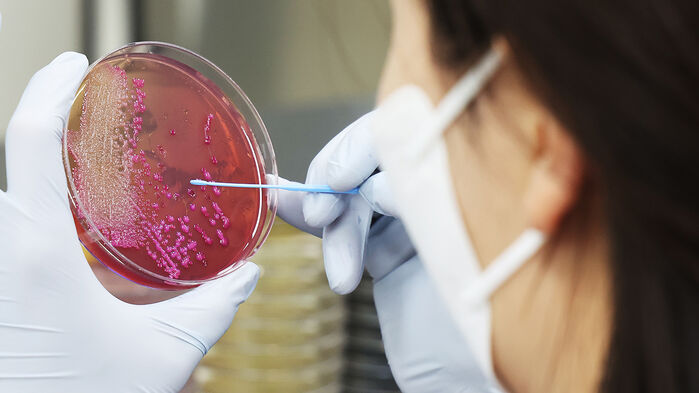
식중독균 배양분리작업 자료화면

SBS 뉴스

▲위 사진은 기사 내용과 관련이 없습니다.
충청권 군부대 여러 곳에서 식중독 의심 환자가 발생한 지 한 달 만에 강원도 한 군부대에서도 집단으로 식중독 증세를 보여 먹거리 안전에 비상이 걸렸습니다.
일부 병사는 심한 복통과 설사 증세를 보이고 병원에 입원한 병사가 있음에도 해당 부대는 보건당국에 즉시 신고조차 하지 않았습니다.
오늘(5일) 언론사 취재를 종합하면 인제군에 있는 육군 12사단 군사경찰대대 소속 병사 30여 명은 지난 1일부터 복통과 설사 등 식중독 의심 증세를 보였습니다.
12사단 관계자는 "환자들 대부분이 경미한 증상을 보여 진료 후에 복귀했고, 다른 장병들과 동선을 분리해서 관리하고 있다"고 설명했습니다.
그러나 예정된 휴가를 나온 병사 중에는 일상생활이 어려울 정도로 심한 구토와 설사를 반복하고 있습니다.
주말 동안 몸살, 발열, 두통, 설사 증세를 겪은 병사 A 씨는 3일 휴가를 나와 이동하던 중 구토와 과호흡으로 인해 의사소통에 어려움을 겪고, 손에 쥐가 나고 오그라드는 증상을 겪었습니다.
A 씨는 응급조치와 수액 치료를 받고 증상이 다소 완화되어 집에서 머물고 있으나 계속된 구토와 설사로 인해 증상이 악화할 경우 대학병원 입원까지 고려하고 있습니다.
또 다른 병사 역시 하루에 30번 이상 설사하고, 새벽에도 복통 탓에 화장실을 드나들고 있으며, 두통과 매스꺼움, 식은땀, 오한 등으로 인해 정상 생활에 어려움을 겪는 것으로 전해졌습니다.
병사 중에는 부대 인근 병원에 입원 치료 중인 환자도 1명 있는 것으로 파악됐습니다.
그러나 부대 측은 언론사 취재가 시작된 지난 4일에서야 보건소에 이 같은 사실을 알렸습니다.
식중독 발생원인 조사절차에 관한 규정상 2명 이상이 동일한 식품을 섭취한 뒤 식중독 의심 증상을 보이면 보건소에 신고해야 하고, 감염병 대응 매뉴얼상 집단 식중독 의심 사례의 경우 주말에도 신고가 이뤄지면 즉시 역학조사에 나서는 체계가 마련돼있으나 부대 측은 지난 4일 오후 보건소에 신고했습니다.
12사단 관계자는 "지난 3일 사단 의무대대에서 위생점검에 나서 식자재와 부식을 비롯해 취사장 전반에 걸쳐 위생 점검을 했으나 특이사항은 없었다"며 자체 점검에 이어 보건소에 신고했을 뿐 취재가 시작되고 나서야 신고한 것은 아니라는 취지로 설명했습니다.
A 씨의 가족은 "충청권 군부대에서 집단으로 식중독 의심 증세가 발생한 지 한 달도 지나지 않아 또다시 재발한 건 군 급식과 식자재 관리 체계에 문제가 있다는 방증"이라고 말했습니다.
이어 "국가가 국민의 자녀를 맡아 보호하는 공간에서 기본적인 먹거리 안전조차 보장되지 않는 현실은 결코 용납될 수 없다"며 "시간이 지나면 조용히 덮이는 군 내 급식 사고로 끝날 일이 아니라 반복되는 군 급식 안전 문제에 대한 제도적인 대책 마련이 필요하다"고 강조했습니다.
(사진=연합뉴스)
Copyright Ⓒ SBS. All rights reserved. 무단 전재, 재배포 및 AI학습 이용 금지
SBS 뉴스